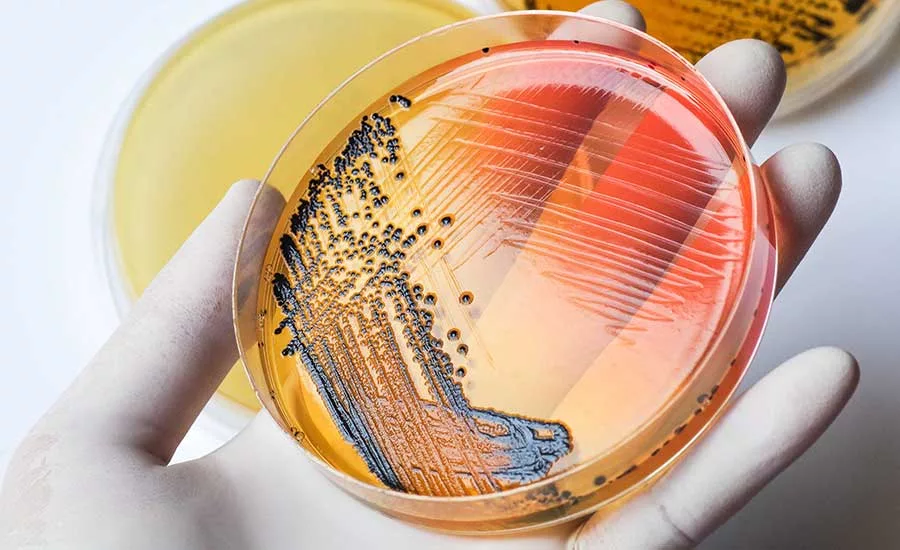
foodborn illness

What Foods Make People Sick? This Federal Collaboration Seeks to Find Out
IFSAC strives to improve the data and methods used to estimate the sources of foodborne illnesses by focusing on four priority pathogens
In the early 2000s, federal food safety agencies knew that certain foods were often linked to outbreaks sickening millions of people every year from harmful bacteria. But little was known about the proportions of illnesses linked to specific foods. At times, this information gap made it difficult to assess the effectiveness of the policies and interventions designed to reduce illnesses. The agencies began looking into their respective data and realized that they needed to work more closely to uncover answers. In 2011, leaders and analysts from the U.S. Centers for Disease Control and Prevention (CDC), the U.S. Food and Drug Administration (FDA), and the U.S. Department of Agriculture's Food Safety and Inspection Service (USDA-FSIS) came together to form the Interagency Food Safety Analytics Collaboration (IFSAC) to address this problem.1
IFSAC strives to improve the data and methods used to estimate the sources of foodborne illnesses and to enhance federal strategies for protecting public health through food safety. The group focuses on illnesses caused by four priority pathogens—Salmonella, Escherichia coli O157 (E. coli), Listeria monocytogenes, and Campylobacter. IFSAC focuses on these pathogens because of the frequency and severity of the illnesses they cause and because targeted interventions can significantly reduce the occurrence of these illnesses. For over a decade, federal agencies have been relying on IFSAC to inform food safety initiatives, interventions, and policies. IFSAC work is also frequently shared in international settings, such as the International Association for Food Protection (IAFP) annual meeting and the International Conference on Emerging Infectious Diseases (ICEID).
Categorizing Foods Implicated in Outbreaks
One of IFSAC's first endeavors was the development of a harmonized food categorization scheme.2 Published in 2017, the document categorizes foods by type and how they have been processed.3 Previous methods for food categorization excluded many multiple-ingredient foods and did not consider whether or how the food had been processed. The specificity of the IFSAC scheme helps establish and visualize more links between different food products. This approach has been integrated into many public health surveillance systems. For example, the CDC National Outbreak Reporting System (NORS)4 assigns IFSAC categorizations to outbreaks reported by local, state, and territorial health departments so that analyses of outbreak data can use these categories to better understand and prevent foodborne disease outbreaks. This scheme has also been incorporated into the National Institutes of Health's National Center for Biotechnology Information Pathogen Detection System5 and FDA's GenomeTrakr Network,6 which aim to provide publicly accessible information on whole genome sequencing (WGS) data for select foodborne pathogens.
Estimating Attribution
Since 2012, IFSAC has published annual attribution estimates using over 20 years of data from surveillance systems that collect information on outbreaks of foodborne illness reported to the CDC NORS. IFSAC applies a statistical model to estimate the foods responsible for all foodborne illness in the U.S. linked to the IFSAC priority pathogens.7 These public reports emphasize the latest data while including historical data to better assess the sources of foodborne illness in the U.S.8
Federal agencies use IFSAC estimates to inform strategic planning and risk-based decision-making, which helps them evaluate the impact of their current policy and, at times, revise regulations, policies, and standards for industry. For example, IFSAC attribution estimates informed FSIS' proposed framework to reduce Salmonella illnesses attributable to poultry.9 Specifically, the estimates were used in a quantitative risk assessment to calculate the total number of Salmonella illnesses attributable to poultry. This risk assessment provided scientific support for the framework.
Beyond their role in helping shape federal priorities and possible interventions, these annual estimates also help scientists; federal, state, and local policymakers; the food industry; consumer advocacy groups; and the public in recognizing new concerns and ascertaining whether current prevention-oriented measures are working.
Other Current and Future IFSAC Work
While data from surveillance systems can be summarized to determine which foods are most commonly associated with foodborne illness outbreaks, only a small proportion (approximately 5 percent) of cases of foodborne illness are associated with an outbreak. For the remaining sporadic cases, it is often difficult to identify the specific food that made someone sick. IFSAC is currently working on projects to better integrate sporadic case data into annual estimates that, at the moment, rely heavily on outbreak data.
Looking for quick answers on food safety topics?
Try Ask FSM, our new smart AI search tool.
Ask FSM →
IFSAC has many additional cross-cutting priorities for food safety data collection, analysis, and use. In 2023, IFSAC published its priorities for 2024–2028, which include exploring new data sources and alternative methods to better estimate foodborne illness attribution.10 The primary aim of this exploration is to produce more reliable and generalizable source attribution estimates for a priority pathogen, Campylobacter. IFSAC further hopes to expand its priority pathogen list to generate annual attribution estimates for non-O157 Shiga-toxin producing E. coli (STEC), as non-O157 STECs are an important cause of foodborne illness in the U.S. and of increasing importance to federal food safety regulatory agencies. Eventually, IFSAC would also like to incorporate data on non-foodborne sources, such as animal and environmental sources, into its statistical models to better refine and contextualize foodborne illness source attribution. As IFSAC's priority pathogens also spread through contact with people, water, and other environmental sources, incorporation of illness data from non-foodborne sources will help generate more accurate estimates for foodborne illness source attribution.
By bringing together data from CDC, FDA, and USDA-FSIS, and developing sound analytical methods, IFSAC continues to build upon its approach to estimating the sources of foodborne illness and identifying food safety priorities to protect public health. These efforts underscore how data can empower government agencies, industry, consumer groups, and other stakeholders to implement advanced and innovative food safety approaches to protect consumers.
References
- Interagency Food Safety Analytics Collaboration (IFSAC). "About IFSAC." 2024. https://www.cdc.gov/ifsac/about/index.html?CDC_AAref_Val=https://www.cdc.gov/foodsafety/ifsac/index.html.
- IFSAC. "IFSAC Food Categorization Scheme." 2024. https://www.cdc.gov/ifsac/php/projects/food-categorization-scheme.html.
- Richardson, L.C., et al. "An Updated Scheme for Categorizing Foods Implicated in Foodborne Disease Outbreaks: A Tri-Agency Collaboration." Foodborne Pathogens and Disease 14, no. 12 (2017): 701–710. https://pubmed.ncbi.nlm.nih.gov/28926300/.
- Centers for Disease Control and Prevention (CDC). "National Outbreak Reporting System (NORS)." September 4, 2024. https://www.cdc.gov/nors/about/index.html.
- National Institutes of Health. "National Center for Biotechnology Information Pathogen Detection System." https://www.ncbi.nlm.nih.gov/pathogens.
- U.S. Food and Drug Administration (FDA). "GenomeTrakr Network." Current as of September 17, 2024. https://www.fda.gov/food/whole-genome-sequencing-wgs-program/genometrakr-network.
- Batz, M.B., et al. "Recency-Weighted Statistical Modeling Approach to Attribute Illnesses Caused by 4 Pathogens to Food Sources Using Outbreak Data, United States." Emerging Infectious Diseases 27, no. 1 (2021): 214–222. https://wwwnc.cdc.gov/eid/article/27/1/20-3832_article.
- IFSAC. "Annual Reports on Foodborne Illness Source Attribution Estimates." 2024. https://www.cdc.gov/ifsac/php/annual-reports/?CDC_AAref_Val=https://www.cdc.gov/foodsafety/ifsac/annual-reports.html.
- U.S. Department of Agriculture, Food Safety and Inspection Service (USDA-FSIS). "Salmonella Framework for Raw Poultry Products." August 7, 2024. https://www.fsis.usda.gov/policy/federal-register-rulemaking/federal-register-rules/salmonella-framework-raw-poultry-products.
- CDC. "Interagency Food Safety Analytics Collaboration (IFSAC) Priorities for 2024–2028." 2024. https://www.cdc.gov/ifsac/media/pdfs/IFSACPriorities2024-2028.pdf.
Michael C. Bazaco, Ph.D., M.S. is an Epidemiologist at the U.S. Food and Drug Administration's (FDA's) Human Foods Program (HFP).
Cary Chen Parker, M.P.H. is a Supervisory Consumer Safety Officer at FDA's HFP.
Christina K. Carstens, Ph.D. M.S. is an Epidemiologist at FDA's HFP.
Christopher Waldrop, M.P.H. is a Senior Health Scientist at FDA's HFP.
Reese T. Tierney, M.P.H. is an Epidemiologist at the Centers for Disease Control and Prevention's (CDC's) Enteric Disease Epidemiology Branch.
Daniel Weller, Ph.D. is a Senior Epidemiologist at CDC's Enteric Diseases Epidemiology Branch.
Kelsey Schwarz, Ph.D. is a Health Communications Specialist at CDC's National Center for Emerging and Zoonotic Infectious Diseases.
Andrea Cote, D.V.M., M.P.H., D.A.C.V.P.M. is an Epidemiologist at the U.S. Department of Agriculture Food Safety and Inspection Service's (USDA-FSIS') Office of Public Health Science.
Bailey McWilliams, M.S. is a Public Affairs Specialist with USDA-FSIS.








